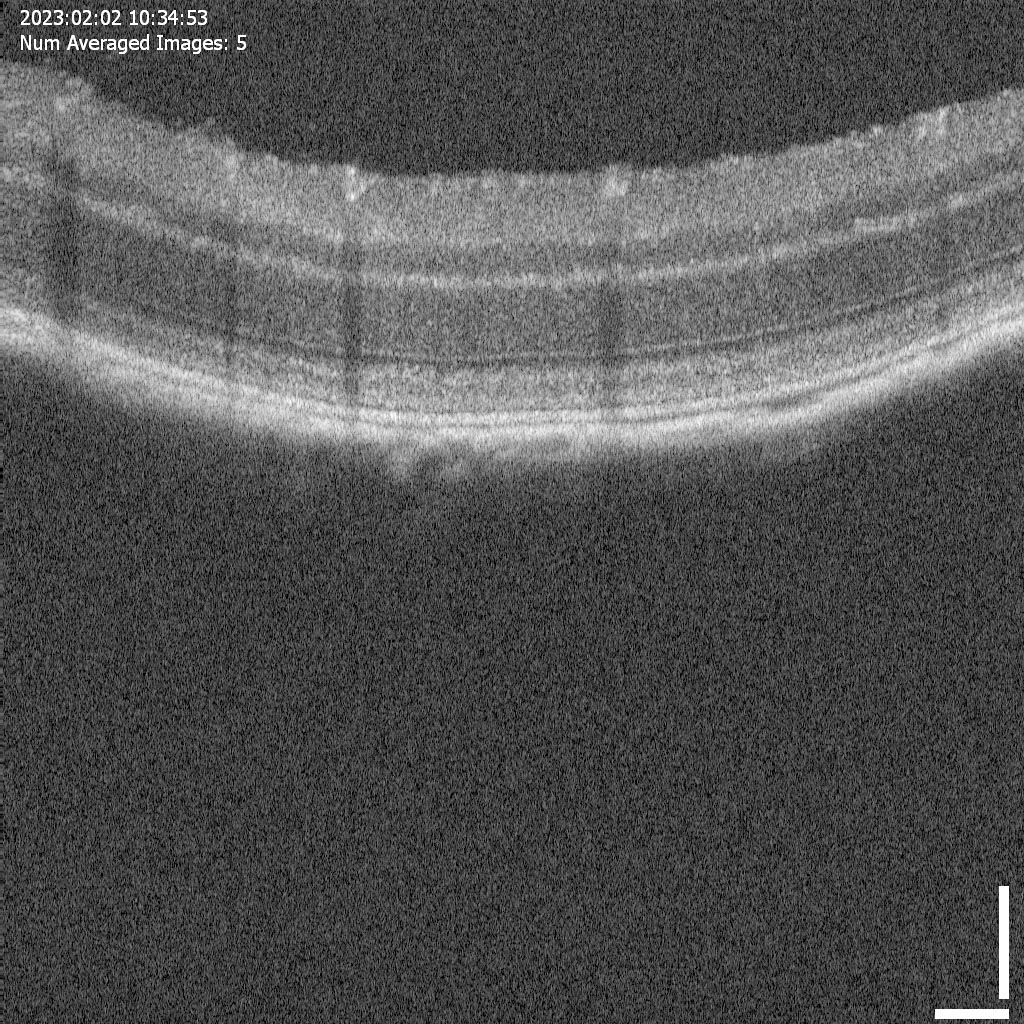

jsc2023e054753 (9/27/2023) --- Optical Coherence tomography image demonstrating the retinal ultrastructure of the mouse retina. Preclinical Validation of a Modifier Gene Therapy to Prevent Spaceflight Associated Oxidative Stress and Apoptosis in Microgravity Mouse Model of Dry Macular Degeneration (Rodent Research-28 or RR-28) tests the effect of a gene therapy on retinal structure and function during spaceflight. (Image courtesy Oculogenex Inc.)
Most NASA images are in the public domain and free to use. Credit NASA as the source. Check NASA's media usage guidelines for details. Images featuring identifiable individuals may require additional permissions.
NASA ID
jsc2023e054753
Date Created
September 27, 2023
Center
JSC
Media Type
image
Download this image in multiple resolutions. All NASA media are free for public use.
Small
480px